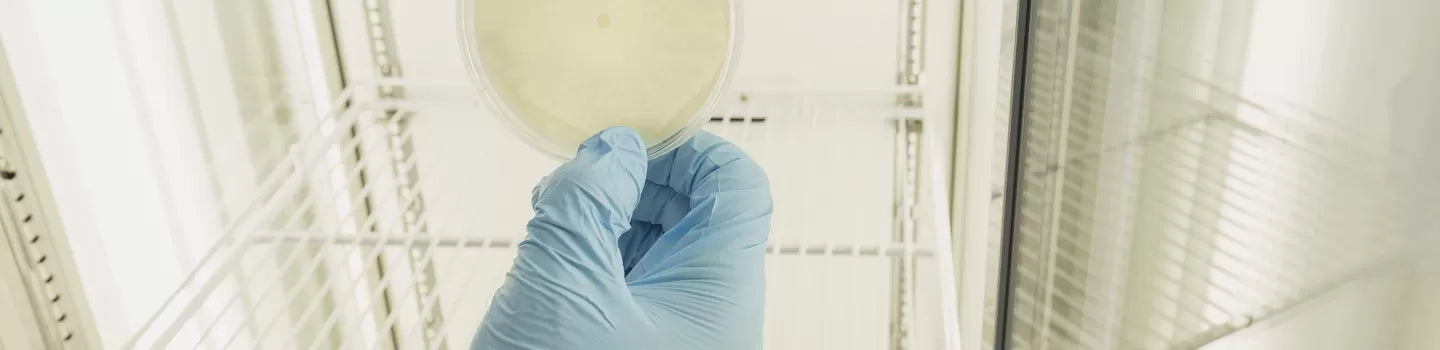

LAB TESTING
Independent laboratory testing, carried out in partnership with Lincoln Agritech, has shown that our formulations significantly improve nail strength and resilience compared to untreated controls.
Independent laboratory testing, carried out in partnership with Lincoln Agritech, has shown that our formulations significantly improve nail strength and resilience compared to untreated controls.
Work was undertaken using model nail plates and a tensile bending test to investigate the efficacy of two formulations provided by Harden Up Limited (Dr Tom cream only and liquid peptide solution + Dr Tom cream). Statistically relevant increases in elongation % at peak (+8.2%) and absorbed energy (+36.6 %) measured between the Dr Tom cream only vs Peptide + Dr Tom cream treatment groups indicated that treating the model nail samples with liquid peptide solution prior to applying the Dr Tom cream assisted in improving nail flexibility and absorbed energy.
Guitar players that use fingerstyle methods (e.g. Flamenco and Classical) require nails that are reliably strong and not prone to breakage. When nails break, they may be augmented with artificial materials (e.g. acrylic nail plates), or porous textiles such as “nail silk” which are then filled with strong glues. These methods are adequate for some players but can cause damage to the underlying nail, and many prefer the natural nail which may take up to six weeks to sufficiently grow back. The client has identified an opportunity to provide the guitar-playing community with an efficacious formulation to maintain strong nails with scientific data to support its functionality. Whilst there are many formulations available that claim to strengthen nails, there are very few that are supported by scientific data.
Using human nail plates collected from volunteers to test formulations is problematic due to the shape, size, and heterogeneity of natural nails which vary markedly even when obtained from the same subject. Often claims rely solely on volunteer studies and subjective responses.
Nail plates are composed of keratin proteins tightly bound to form a hard, crosslinked and resilient material (1). These proteins are arranged in a complex 3-layered structure (2,3). As the nail plate extends out from the nail bed, it is no longer “nourished” by the underlying nail bed and becomes prone to dehydration and breakage.
Lincoln Agritech has developed a novel process for isolating wool keratin cells and thermoforming them into nail-like materials (4). These model nail plates are composed of the same keratin proteins present in nails and as such are promising candidates for testing formulations as they are chemically comparable. In previous work undertaken by Lincoln Agritech for Harden Up Limited, model nail plates were constructed, and a tensile bending test was developed to investigate the efficacy of different nail formulations (5,6). In the first trial, formulation HUv6 was shown to significantly improve the % elongation (+6.3 %) and absorbed energy (+27.7%) properties of the nail compared to the untreated control test group (5). In the second trial, the efficacy of two new formulations (HUv7 only and Peptide + HUv7) were examined and whilst a statistically relevant increase in % elongation was measured between the control vs HuV7 only (+5.4 %) and control vs Peptide + HUv7 (+4.8 %) , the full impact of treatment with these formulations was difficult to fully elucidate because the model nails used were shown to be very strong prior to treatment (6).
In the present work, model nail samples with strength properties comparable to those used in the first trial (5) were prepared and the efficacy of two formulations provided by Harden Up Limited (Dr Tom cream only and Peptide + Dr Tom cream) were investigated using the protocols developed in the previous work.
Fabrication of model nail plates
Keratin model nail plates were prepared from separated wool cortical cells by melding under heat and pressure at temperature close to the proteins’ thermal transition value. This formed translucent sheets (Figure 1, left image), which were then cut to strips of approximately 4-5 mm in width and 0.6-0.9 mm in thickness. The strips were then cut into 15 mm pieces (i.e., the minimum length required for tensile testing) and distributed between 2 treatment groups. A total sample size (N) of 20 pieces per treatment group was used (Figure 1, right image) and rigorous selection of the samples within each group was performed according to sample width and thickness to ensure the mean parameters were within 3% between treatment groups (see Appendix 1).
Figure 1. Model nail sheet (left) and model nail samples sorted into treatment group for testing (right).
At the end of treatment periods a CV001 tensile tester was utilized to determine the maximum bend strength of the test nails. Custom-made parts were manufactured to allow for the tester to apply a known force perpendicular to the grain of the nail. The tester recorded the force and elongation at its peak along with the absorbed energy of the sample which is stated in kgf.mm.
Formulation treatment of model nail plates
The treatment protocol used in this study was modelled on that used in Test 5 of Project 1 which subjected model nail plates to 8 formulation (HUv6) treatments and 6 washes over a period of 10 days (see Report 1657-01 R1). In the current trial, two test formulations provided by Harden Up Limited (Dr Tom cream only and Peptide + Dr Tom cream, see Figure 2 and Table 1) were compared. These formulations were applied 10 times over the period of 14 days to Treatment Groups 1 & 2, as shown in Table 2. For Treatment Group 1, Dr Tom cream was applied onto the model nail samples at a level of 10 mg cream/100 mg of nail sample and rubbed in to both sides by hand for 20-30s before being left to air dry overnight. For Treatment Group 2, the model nail samples were coated twice by immersion in liquid peptide solution (5 mL) for ~30 s and air dried for 1 hour after each coating before Dr Tom cream was applied using the same method described for Treatment Group 1. For both formulation treatment groups, a distilled water wash (15 minute duration) and oven drying step (40oC, 30 minutes) was carried out after 3 formulation treatments, and then every subsequent treatment thereafter (i.e., a total of 8 washes).
Figure 2. Test formulations provided by Harden Up: Dr Tom cream (left) and liquid peptide solution (right).
Table 1. Treatment conditions used during the trial.

Table 2. Summary of treatment regime.
A CV001 tensile tester was used to determine the maximum bend strength of the nails (Figure 3). Custom-made parts were manufactured to allow for the tester to apply a known force perpendicular to the grain of the nail. The tester was set to a constant extension rate of 50 mm/min with a maximum recordable force of 5 kgF. The tester recorded the force and elongation at its peak along with the absorbed energy of the sample which is stated in kgf.mm. A nail width of 4-5 mm was selected for the test material as this fell within the mid-range of the tester’s resolution.

Figure 3. Tensile bending apparatus.
Results
In previous trials, the model nail plates constructed for use in Project 2 were shown to be significantly stronger than those used in Project 1 and this made it difficult to (1) further improve the nail tensile properties and (2) elucidate the full impact of treating the nails with HUv7 or Peptide + HUv7 (see Report 1657-01 R2). In the current study (Project 3), model nail samples with strength properties between those measured in Projects 1 and 2 were prepared (Table 3) and the efficacy of two formulations provided by Harden Up Limited (Dr Tom cream only and Peptide + Dr Tom cream) were investigated.
Table 3. Tensile parameters for control model nail plates.
a Model nail plates were used within 7 weeks of preparation and washed with distilled water (15 minute duration) and oven-dried (35 °C, 2 hr) 6 times over a period of 10 days.
b Model nail plates were used within 1.5 weeks of preparation and washed with distilled water (15 minute duration) and oven-dried (40 °C, 30 min) 8 times over a period of 15 days.
In the current trial, test formulations of Dr Tom cream only or Peptide + Dr Tom cream were compared. 10 formulation treatments were applied over 14 days. A water wash was performed after 3 applications and then after each subsequent application i.e. 8 washes in total. Model nail pieces were oven dried at 40oC for 30 minutes after each water wash.
The average tensile parameters measured for treatment groups are shown in Table 4. Raw data are provided in Appendix 2.
Table 4: Average tensile parameters.

* t test = 2-tailed, type 3, ns = not significant as p > 0.1
Statistically relevant increases in elongation % at peak (+8.2 %) and absorbed energy (+36.6 %) were measured between the Dr Tom cream only vs Peptide vs Dr Tom cream treatment groups.
The statistically relevant increases in elongation % at peak (+8.2 %) and absorbed energy (+36.6 %) measured between the Dr Tom cream only vs Peptide vs Dr Tom cream treatment groups indicates that treating the model nail samples with liquid peptide solution prior to applying the Dr Tom cream assisted in improving nail flexibility and absorbed energy.
The nail plate model material and tensile bending test were applied to determine the effect of nail formulations Dr Tom cream only and Peptide + Dr Tom cream.
Statistically relevant increases in elongation % at peak (+8.2 %) and absorbed energy (+36.6 %) measured between the Dr Tom cream only vs Peptide vs Dr Tom cream treatment groups indicates that treating the model nail samples with liquid peptide solution prior to applying the Dr Tom cream assisted in improving nail flexibility and absorbed energy.
V Kumar, S Sharma, Naveen and P Jalwal. A comprehensive review on human nail. International Journal of Medical and Health research,Vol 3: Issue10; 72-74, October 2017.
H Tohmyoh and M Abukawa. Nanoindentation study of human fingernail for determining its structural elasticity. Skin Res. Technol. 2023;29:e13456. Https//doi.org/10.1111/srt.13456.
L Farran, A R Ennos, M Starkie and S J Eichhorn. Tensile and shear properties of fingernails as a function of a changing humidity environment. Journal of Biomechanics, 42, 1230-1235, 2009.
R J M Kelly G L Krsinic GL, B J Edwards. Use of wool cells in paper composites. AUS 2022903970. 22 Dec 22.
A Roddick-Lanzilotta, T Hughes and R Kelly. Harden Up Limited – Efficacy of formulations on model nail plates (Report 1657-01 R1). Lincoln Agritech Limited. 13 December 2024.
A Cruickshank, B Edwards, T Hughes and R Kelly. Harden Up Limited – Efficacy of formulations on model nail plates (Report 1657-01 R2). Lincoln Agritech Limited. 30 April 2025.
Sorting nails into treatment groups.
* Made into 2 x 20 samples by taking long pieces and cutting at 15mm and distributing between the 2 groups
* Measure width and thickness at middle of 15mm piece. Delete/remove outliers from each set and move samples as needed so all parameter averages within 3 % of each other

